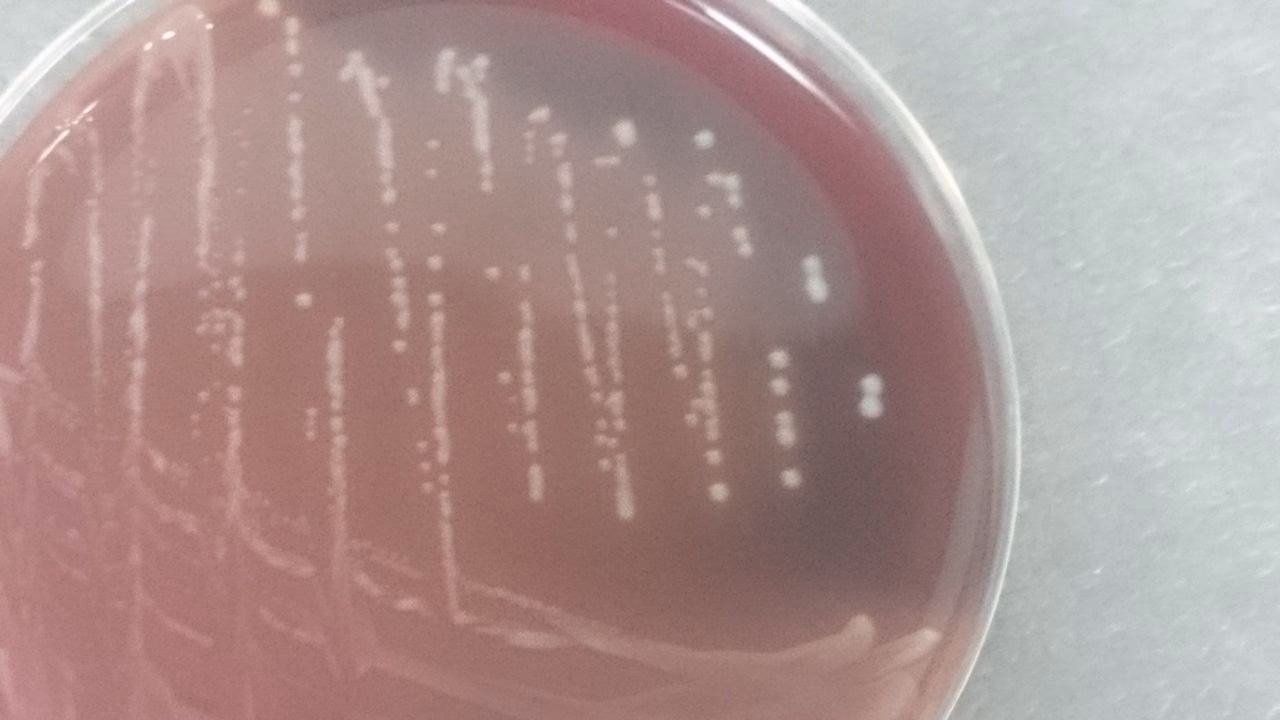
Are lactobacilli in blood cultures a clinical significance?

06/07/2009
Lactobacillus er et navn, de fleste forbinder med sunde tarme og probiotiske produkter som yoghurt og kosttilskud. Disse bakterier er kendt som 'gode' bakterier, der spiller en afgørende rolle i vores fordøjelsessystem og generelle velbefindende. Men hvad sker der, når disse normalt harmløse mikroorganismer findes et sted, hvor de absolut ikke hører hjemme – i blodbanen? Tilstedeværelsen af lactobaciller i en blodkultur er en sjælden, men potentielt livstruende tilstand kendt som Lactobacillus bakteriæmi. Denne opdagelse bliver ofte afvist som en simpel forurening fra prøvetagningen, men nyere forskning og kliniske erfaringer understreger, at det kan være et alvorligt alarmsignal om en underliggende, kritisk sygdom, som kræver øjeblikkelig opmærksomhed.

Hvad er Lactobacillus Bakteriæmi?
Lactobacillus bakteriæmi er defineret ved tilstedeværelsen af Lactobacillus-bakterier i en persons blodbane. Selvom det er en yderst sjælden forekomst, der kun udgør omkring 0,1% af alle positive blodkulturer, er dens kliniske implikationer betydelige. Fordi Lactobacillus er en naturlig del af floraen i munden, mave-tarmkanalen og det kvindelige urogenitale system, er det let at antage, at en positiv test skyldes kontaminering under blodprøvetagningen. Men at ignorere dette fund kan have fatale konsekvenser. For at skelne mellem en reel infektion og forurening, anbefaler eksperter, at diagnosen bekræftes, hvis bakterien isoleres i mindst to separate blodkulturer, eller hvis den findes i blodet og på et andet normalt sterilt sted i kroppen.
Risikofaktorer og den Skjulte Fare
Hvem er i risiko for at udvikle denne sjældne, men alvorlige tilstand? Forskning peger på en række disponerende faktorer, der ofte er forbundet med en svækket krop eller en kompromitteret barriere mellem tarmen og blodbanen. At forstå disse risikofaktorer er afgørende for at kunne identificere patienter, der kræver en grundigere undersøgelse.
Primære Risikogrupper
- Alvorlige Underliggende Sygdomme: Patienter med alvorlige eller dødelige komorbiditeter, såsom kræft, diabetes eller leversygdom, udgør den største risikogruppe.
- Immunsuppression: Personer med et svækket immunforsvar, enten på grund af sygdom (f.eks. HIV) eller medicinsk behandling (f.eks. kemoterapi eller organtransplantation), er mere sårbare.
- Langvarig Hospitalsindlæggelse: Længerevarende ophold på hospitaler, især på intensivafdelinger, øger risikoen for infektioner.
- Kirurgiske Indgreb: Nylige operationer, især i mave-tarm-regionen, kan skabe en indgangsport for bakterier til blodbanen.
- Indlagte Katetre: Permanente venekatetre og andre medicinske anordninger kan fungere som en direkte vej for bakterier ind i cirkulationen.
En af de mest kritiske mekanismer bag Lactobacillus bakteriæmi er et fænomen kendt som bakteriel translokation. Dette sker, når tarmens slimhindebarriere bliver beskadiget eller utæt. Under normale omstændigheder holder denne barriere effektivt tarmbakterier adskilt fra resten af kroppen. Men ved tilstande som alvorlig sygdom, iltmangel i tarmen (iskæmi) eller inflammation, kan barrieren brydes ned. Dette tillader bakterier som Lactobacillus at 'vandre' fra tarmen og ind i blodbanen, hvor de kan forårsage en systemisk infektion (sepsis). Et eksempel er iskæmisk colitis, en tilstand hvor blodforsyningen til tyktarmen er reduceret, hvilket fører til vævsskade og øget tarmpermeabilitet. Her fungerer bakteriæmien som et direkte tegn på en alvorlig underliggende patologi.
Klinisk Betydning og Dødelighed
Den kliniske klinisk signifikans af at finde Lactobacillus i blodet kan ikke undervurderes. Studier har vist en alarmerende høj dødelighed forbundet med tilstanden. Omkring 26% af patienterne dør inden for den første måned efter diagnosen, og tallet stiger til hele 48% inden for et år. Disse tal understreger, at Lactobacillus bakteriæmi ikke er en harmløs observation, men en markør for alvorlig sygdom. En multivariat analyse har vist, at den mest betydningsfulde prædiktor for dødelighed er tilstedeværelsen af alvorlige underliggende sygdomme. Omvendt er chancerne for overlevelse markant bedre for patienter, der modtager en hurtig og effektiv antibiotikabehandling, der er målrettet mod den specifikke Lactobacillus-stamme.
Diagnostik og Behandling: En Målrettet Indsats
Når Lactobacillus påvises i en blodkultur, er det første skridt at bekræfte, at det er en reel infektion og ikke en forurening. Hvis infektionen bekræftes, skal der straks igangsættes en eftersøgning efter kilden. Dette indebærer en grundig klinisk undersøgelse og ofte billeddiagnostik som CT-scanninger eller endoskopi (f.eks. koloskopi) for at identificere problemer som colitis, bylder eller andre infektionsfoci. Endokarditis (betændelse i hjertets indre hinde) skal også udelukkes, da det er en af de hyppigst rapporterede infektioner i forbindelse med denne type bakteriæmi.
Behandlingen skal være aggressiv og målrettet. En af de største udfordringer er, at Lactobacillus-bakterier er naturligt resistente over for mange almindeligt anvendte antibiotika, herunder vancomycin. Derfor er følsomhedstestning af den isolerede bakteriestamme absolut afgørende for at vælge den rigtige medicin. Uden denne test risikerer man at behandle i blinde med et ineffektivt lægemiddel.
Antibiotika Valg: Følsomhed er Nøglen
Den følgende tabel giver et generelt overblik over antibiotika, som Lactobacillus-stammer ofte er følsomme eller resistente over for. Det er dog vigtigt at huske, at dette kan variere, og at specifik testning altid er nødvendig.
| Typisk Følsom (Ofte Effektiv) | Typisk Resistent (Bør Undgås Uden Test) |
|---|---|
| Ampicillin | Vancomycin |
| Piperacillin-tazobactam | Cephalosporiner |
| Carbapenemer (f.eks. Meropenem) | Metronidazol |
| Clindamycin | Fluorquinoloner |
Behandlingen bør fortsætte i mindst 7-10 dage efter, at den første negative blodkultur er opnået, for at sikre, at infektionen er fuldstændig udryddet.
Ofte Stillede Spørgsmål (FAQ)
Er lactobaciller altid farlige i blodet?
Ja. Selvom bakterien er gavnlig i tarmen, er blodbanen et sterilt miljø. Tilstedeværelsen af enhver bakterie i blodet (bakteriæmi) er unormal og et tegn på, at kroppens forsvarsmekanismer er blevet brudt. For Lactobacillus indikerer det ofte en alvorlig, underliggende sygdomstilstand.

Kan man få Lactobacillus bakteriæmi af at indtage probiotika?
Det er ekstremt sjældent, men det kan forekomme, især hos meget sårbare individer som kritisk syge patienter på intensivafdelinger eller personer med stærkt nedsat immunforsvar. For den generelle, sunde befolkning er risikoen forsvindende lille. I de fleste tilfælde stammer infektionen fra patientens egen tarmflora.
Hvorfor er det så vigtigt at finde den underliggende årsag?
Fordi bakteriæmien i sig selv er et symptom, ikke den primære sygdom. At behandle infektionen i blodet med antibiotika er kun en del af løsningen. Hvis den underliggende årsag, f.eks. en perforeret tarm eller en byld, ikke bliver identificeret og behandlet, vil infektionen sandsynligvis vende tilbage, og patientens tilstand vil ikke forbedres.
Hvordan kan laboratorier forbedre diagnostikken?
Laboratorier spiller en nøglerolle ved ikke at afvise fundet som forurening for hurtigt, især hvis patienten er klinisk dårlig. Det er vigtigt at udføre rutinemæssig følsomhedstestning for anaerobe bakterier som Lactobacillus, selvom det kræver specifikke anmodninger. En tæt dialog mellem mikrobiologer og de behandlende læger er afgørende for at sikre den bedste patientbehandling.
Konklusion: Et Alarmsignal der Skal TAGES Alvorligt
Konklusionen er klar: Fundet af Lactobacillus i en blodkultur er en klinisk signifikant begivenhed, der aldrig bør ignoreres. Det fungerer som et potentielt varsel om en alvorlig og ofte skjult patologi, der kræver øjeblikkelig og grundig udredning. Ved at anerkende risikofaktorerne, forstå mekanismen bag bakteriel translokation og insistere på korrekt diagnostik og målrettet behandling baseret på følsomhedstestning, kan læger forbedre prognosen markant for disse kritisk syge patienter. At afvise dette fund som en simpel forurening er en farlig fejltagelse, der kan koste liv.
Hvis du vil læse andre artikler, der ligner Lactobacillus i Blodkulturer: Klinisk Betydning, kan du besøge kategorien Sundhed.
